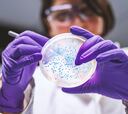

AS USA

Premier League
The Rice is right

Attacks on Venezuela
Who takes power after Maduro’s removal in Venezuela?

Premier League
City lose ground on Arsenal


Premier League
Pedestrian Liverpool amble to goalless draw


Celebrations
New Year’s Eve in Times Square performers

Premier League
Arsenal show Villa who's boss

Space exploration
Date for Moon return revealed
Page28













